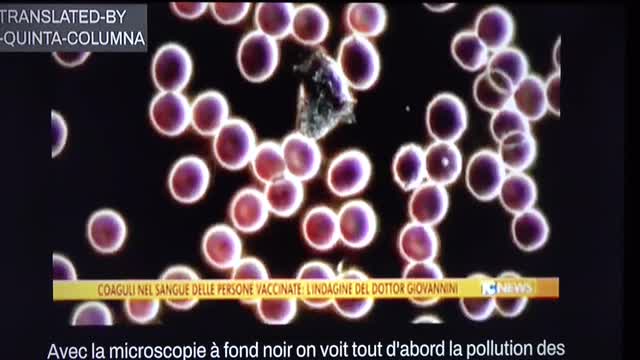
RPV videos reporter

Premium Only Content
This video is only available to Rumble Premium subscribers. Subscribe to
enjoy exclusive content and ad-free viewing.
RPV videos reporter
3 years ago
Des preuves scientifique !!!! Voilà !!!!
Loading 1 comment...
-
 5:12
5:12
Blackstone Griddles
13 hours agoApple Pie Pancakes on the Blackstone Camping Griddle
3.76K -
 44:02
44:02
CarlCrusher
23 hours agoFormer Green Beret Mike Battista can Summon UAP using Psionics - Part 4
5.03K5 -
 44:31
44:31
Damon Imani
15 hours agoDamon VS The View | Best of 2025
4.13K4 -
 28:31
28:31
Living Your Wellness Life
17 hours agoShould You Shower Every Day?
6.31K4 -
 1:00:36
1:00:36
A Cigar Hustlers Podcast Every Day
1 day agoHustler Every Week Day Episode 426 "What To Know Before Its To Late!"
3.97K1 -
 LIVE
LIVE
BEK TV
22 hours agoTrent Loos in the Morning - 12/11/2025
151 watching -
 1:34:34
1:34:34
Tucker Carlson
10 hours agoWhy Are We Defending Mass Murder in Gaza? Because Our Greatest Ally Demands It
90.3K408 -
 30:01
30:01
James Klüg
16 hours agoA Murder Capital of America Protests ICE DEPORTING Criminals
12.4K9 -
 26:10
26:10
Michael Knowles
15 hours agoFormer Diddy Escort Reflects on Turning to Christianity | Michael & Shawn Dearing
22.5K13 -
 14:12
14:12
Actual Justice Warrior
2 days agoMamdani Promises To Turn NYC Into San Francisco
20.8K10